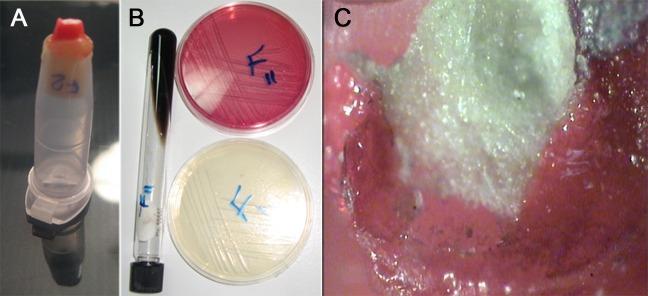

不同根尖充填材料的细菌微渗漏与染料微渗漏比较
Comparison of bacterial and dye microleakage of different root-end filling materials.
作者信息
Kazem Majid, Eghbal Mohammad Jafar, Asgary Saeed
机构信息
Department of Endodontics, Dental Research Center, Shahid Beheshti University of Medical Sciences, Tehran, Iran.
出版信息
Iran Endod J. 2010 Winter;5(1):17-22. Epub 2010 Feb 20.
INTRODUCTION
The provision of an effective apical seal is an essential factor when choosing an appropriate material for success of root-end surgeries. Root-end resection, preparation and obturation should provide an adequate apical seal. The aim of this in vitro study was to investigate bacterial and dye microleakage of four different root-end filling materials and compare the efficacy of these two methods.
MATERIALS AND METHODS
Fifty-six single-rooted teeth with intact and straight roots were randomly assigned into four study groups of 12 each and two control groups of three each. After decoronation, root canals were prepared up to file size #40 using step back technique; then, they were filled with gutta-percha and AH26 sealer. Root-ends were resected 3 mm above the root-end and 3 mm deep cavities were prepared. Root-end cavities were filled with amalgam, Root Mineral Trioxide Aggregate (Root MTA), White ProRoot MTA (WMTA), and calcium enriched mixture (CEM) cement. Bacterial leakage was investigated in Trypticase Soy Broth (containing Enterococcus faecalis) after 70 days and 1% methylene blue dye leakage was assessed after 72 hours. Complete dye leakage was checked using stereomicroscope (×40). Data were statistically analyzed using Fisher Exact test. For pair comparison between the two methods Kapa agreement was utilized.
RESULTS
After 70 days there was 100% bacterial leakage in amalgam, and CEM cement, 91.7% in WMTA, and 75% in Root MTA. This difference was not significantly different. The difference in complete dye leakage was also not significant (WMTA and CEM cement 16.7%, Amalgam and Root MTA 33.3%).
CONCLUSION
There was no significant measure of agreement between dye and bacterial penetration along root-end fillings. CEM cement was not significantly different from currently used retrofilling materials e.g. WMTA.
引言
在为根尖手术的成功选择合适材料时,提供有效的根尖封闭是一个关键因素。根尖切除、预备和充填应提供足够的根尖封闭。本体外研究的目的是调查四种不同根尖充填材料的细菌和染料微渗漏情况,并比较这两种方法的效果。
材料与方法
56颗牙根完整且笔直的单根牙被随机分为四个研究组,每组12颗,两个对照组,每组3颗。去冠后,采用逐步后退技术将根管预备至40号锉;然后,用牙胶尖和AH26封闭剂充填。在根尖上方3mm处切除根尖,并制备3mm深的洞形。根尖洞形用银汞合金、根用三氧化矿物凝聚体(Root MTA)、白色ProRoot MTA(WMTA)和富钙混合物(CEM)水门汀充填。70天后在胰蛋白胨大豆肉汤(含粪肠球菌)中研究细菌渗漏情况,72小时后评估1%亚甲蓝染料渗漏情况。使用体视显微镜(×40)检查染料完全渗漏情况。数据采用Fisher精确检验进行统计学分析。对于两种方法之间的配对比较,采用Kapa一致性检验。
结果
70天后,银汞合金和CEM水门汀组细菌渗漏率为100%,WMTA组为91.7%,Root MTA组为75%。这种差异无统计学意义。染料完全渗漏的差异也无统计学意义(WMTA和CEM水门汀组为16.7%,银汞合金和Root MTA组为33.3%)。
结论
沿根尖充填物的染料和细菌渗透之间没有显著的一致性测量结果。CEM水门汀与目前使用的倒充填材料如WMTA相比无显著差异。